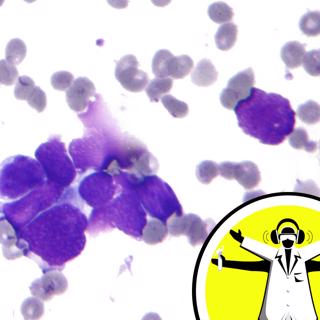
Cutting Edge in Cancer

Sniff! Sniff!
This week, smells, pheromones and anosmia. We talk to a patient with no sense of smell, hear why odours might be more down to the way molecules vibrate that how they are shaped, we look at the role that genes play in what we can smell and hear how pheromones affect how we feel. Plus, in the news, the legacy of double Nobel laureate Fred Sanger who died this week, a new water-repelling material which rejects water faster than ever before, an ode to World Toilet Day, the swarm of tiny satellites which are helping to miniaturise space missions, and we hear about the bacteria that have acquired... Like this podcast? Please help us by supporting the Naked Scientists
26 Nov 201353min

Restore, repair, retain!
This week we discover how we repair and restore everything from ancient manuscripts to the human heart! The team visits the BBC to find out how recently re-discovered episodes of the classic sci-fi series Dr Who were restored and find out about the three million pound project to develop self healing concrete. Plus, in the news, how Typhoon Haiyan has affected the Philippines, where in the world wolves first evolved into dogs, the new drug which could tackle persistent infections and the satellite database which can monitor deforestation from space... Like this podcast? Please help us by supporting the Naked Scientists
19 Nov 201354min

Stopping Multiple Sclerosis
What is multiple sclerosis (MS), what causes it, why do some people suffer from it, and how can we treat it? This week we hear about a drug that can halt the disease in its tracks for some patients, and how scientists screening chemicals that trigger the brain to make new myelin have stumbled on a therapy that might reverse the symptoms for some sufferers. Plus, in the news, why the US and India are launching probes to Mars within weeks of each other, where the meteor which exploded over Russia in February 2013 came from, how Prozac makes the brain more plastic, and the stem cells which... Like this podcast? Please help us by supporting the Naked Scientists
12 Nov 201358min
Cutting Edge in Cancer
From detecting tumour DNA in our bloodstreams to making cancer cells stand out in an MRI scan, this week, coinciding with the NCRI Cancer Conference, we explore how best ways to detect cancer and monitor tumours during treatment. Plus, in the news, what a dog's wagging tail can tell you about its mood, the chemistry behind fireworks, how wind farms could be made up to 30% more efficient just by moving the turbines around, and the electronic blood that could help to shrink supercomputers... Like this podcast? Please help us by supporting the Naked Scientists
5 Nov 201355min

Extreme Geology
Live on location at the Cambridge Science Centre, Chris Smith, Dave Ansell, Ginny Smith and guests James Jackson, an Earth Scientist, Tehnuka Ilanko, a volcanologist, and Arwen Deuss, a seismologist, pit their wits against the assembled public as they tackle the extreme Earth. Plus Dave and Ginny make a flame tornado, a volcanic crater and explain why acid rain can be so damaging... Like this podcast? Please help us by supporting the Naked Scientists
29 Okt 201359min

Stopping Superbugs
What is the scale of the superbug problem? How much is antibiotic resistance costing? Can new antibiotics be made that cannot be bypassed by bacteria? And what new drugs are already in the pipeline. In this infectious episode of the Naked Scientists, we put the rise of antimicrobial resistance under the microscope and ask what scientists are doing to combat the problem. Plus, why the abominable snowman hasn't been discovered...yeti, 46-million-year-old blood from a fossilised mosquito, phage therapy for C. diff and the brain wash-out that happens when we sleep... Like this podcast? Please help us by supporting the Naked Scientists
19 Okt 201354min

Tunnelling Under London
How do you dig a 26 mile tunnel beneath a city and below the water table? This week we drop in on Crossrail, who are busy constructing a new commuter line below the UK capital, to discover how massive tunnels are made in the modern era. Plus, we take a walk along the World's first and oldest tunnel built below a river to hear how it was made, and we find out what present-day tunnelling is turning up of London's past. Also, news of a drug that can repair the brain damage done by multiple sclerosis, and a planet found floating alone in interstellar space... Like this podcast? Please help us by supporting the Naked Scientists
14 Okt 201354min

Science Centre Showoff
Live on location at the Cambridge Science Centre, Chris Smith, Dave Ansell, Ginny Smith and guests Rod Jones, an atmospheric chemist, Margaret Stanley, an HPV cancer researcher, and Caroline Goddard, jet engine metallurgist, pit their wits against the assembled public. Plus Dave and Ginny make crisp packet fireworks, prove you can't be heard screaming in space and make an elastic-band-powered fridge... Like this podcast? Please help us by supporting the Naked Scientists
7 Okt 201354min





















